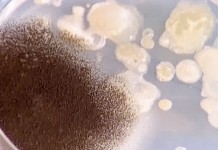
Программа "Здоровье" от 8 мая 2004 г.

Архив
Гипертония: факторы риска
Каковы факторы риска, способствующие повышению артериального давления? Как удержаться и не навредить здоровью, когда вокруг столько соблазнов?
История Игоря Иванова
Игорь Иванов стал первым в нашей стране испытателем кибернетической ноги – современного протеза, оборудованного специальным компьютером, и позволяющего человеку двигаться абсолютно свободно.
Программа "Здоровье" от 29 мая 2004 г.
• Строительство детского реабилитационного центра • Новый метод идентификации личности • Правда жизни: история Игоря Иванова • Советы дачникам: лекарственные растения • Гипертония: факторы риска • Медицинские новости • Детская рубрика: изжога.
Первая помощь при порезах
Каковы правила оказания первой помощи человеку, который порезался.
Лекарственные деревья
Программа "Здоровье" открывает дачный сезон вместе с телеведущей Светланой Сорокиной. Почему на дачном участке вы должны посадить можжевельник и тую, чем они полезны для здоровья человека?
Как правильно лечить гипертонию
Суточный мониторинг артериального давления – самый современный метод, который позволяет назначить пациенту правильные лекарственные препараты и установить точное время их приема. Какими лекарственными препаратами нельзя лечить гипертонию?
История Валентина Михайловича Филиппова
Валентину Михайловичу Филиппову поставили диагноз "плоскоклеточный рак". Врачи предложили ему избавиться от смертельно опасной опухоли с помощью лазера и фотодинамической терапии.
Программа "Здоровье" от 22 мая 2004 г.
• Как правильно лечить гипертонию • Правда жизни: история Филиппова В. М. • Дозу солнечной энергии определят кристаллы • Советы дачникам: лекарственные деревья • Детская рубрика: первая помощь при порезах.
Первый год самостоятельной жизни
Год назад сиамских близнецов Зиту и Гиту
Программа "Здоровье" от 15 мая 2004 г.
• Памяти Бориса Васильевича Петровского • ДЦП – это уже не приговор • Зита и Гита
Памяти Бориса Васильевича Петровского
Ушел из жизни Борис Васильевич Петровский – один из самых известных российских хирургов. Он одним из первых в мире сделал операцию на открытом сердце, первое аортокоронарное шунтирование, первую операцию при аневризме аорты и первую пересадку почки.
Кровь
Почему кровь красная, зачем она нужна.
ДЦП – это уже не приговор
История маленькой девочки Дуняши, которая благодаря уникальной методике, разработанной профессором Козявкиным В. И., сделала первый в своей жизни самостоятельный шаг.
Поллинозы
Если у вас насморк и слезятся глаза – вполне возможно, что это симптомы не банальной простуды, а аллергии. Узнать, что же мешает вам нормально жить, а также назначить правильное лечение, поможет специальное исследование.
Где больше всего микробов?
Где больше всего микробов: в туалете, на деньгах или на поверхности рабочего стола? Программа "Здоровье" решила провести необычный эксперимент, чтобы ответить на этот вопрос.
Сердце – вечный двигатель
Какую работу выполняет сердце, почему его называют вечным двигателем, сколько ударов в день оно совершает.
Правила измерения артериального давления
В порядке ли ваше артериальное давление? Как правильно его измерять, что для этого необходимо, какое давление считается нормальным?
Программа "Здоровье" от 8 мая 2004 г.
• Художественная реставрация зубов • Медицинские новости • Правила измерения артериального давления • Поллинозы • Острая боль в животе • Где больше всего микробов? • Как бороться с морщинами • Детская рубрика: сердце – вечный двигатель.